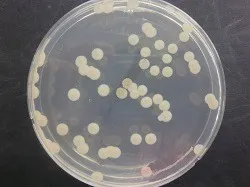

カビの調査・検査で「見えない不安」を数値化|カビ菌検査・同定検査・空気質測定で原因を可視化する重要性
2026/01/20
カビの調査・検査で「見えない不安」を数値化|カビ菌検査・同定検査・空気質測定で原因を可視化する重要性
「カビ臭い気がする」「苦情が出ている」その段階こそ要注意。法人・施設向けカビ調査で現状を正確に把握
「最近、室内がカビ臭い気がする」「清掃しても臭いが取れない」「従業員や入居者から咳や体調不良の声が上がっている」――このようなお悩みは、実は多くのオフィス・店舗・医療施設・福祉施設・集合住宅で発生しています。しかしその一方で、「どこにカビがあるのかわからない」「本当にカビが原因なのか判断できない」といった理由から、対策が後回しになってしまうケースも少なくありません。
現代の建物は高気密・高断熱化が進み、空気の流れや湿気の滞留が起こりやすい構造になっています。そのため、壁の中や天井裏、床下など、普段目に見えない場所でカビが発生・拡散していることも珍しくありません。目視だけで判断することは非常に難しく、感覚や経験だけに頼った対応では、問題の本質を見誤るリスクがあります。
そこで重要になるのが、**カビの調査・検査による「見える化」**です。カビ菌検査や真菌検査、空気質測定を行うことで、室内環境にどの程度のカビ菌が存在しているのか、どの種類のカビが検出されるのかを数値やデータとして把握できます。これは、感情論や憶測ではなく、客観的な根拠に基づいて現状を判断するための大切なステップです。
MIST工法®カビバスターズ東京では、一般社団法人微生物対策協会と連携し、信頼性の高い真菌(カビ菌)検査を重視しています。また、室内の建材の含水率検査、ファイバースコープを用いた壁内調査、風量計による負圧検査など、多角的な調査を行うことで、カビが発生した原因を徹底的に追究します。原因改善を行わなければ、現代の建物ではカビが再発する可能性が非常に高いためです。
「手に負えない」「自分たちでは判断できない」と感じたカビトラブルこそ、専門家への相談が重要です。関東地方でカビ問題に不安を感じている法人様・施設管理者様・個人の方は、まずは真菌検査による現状把握から始めてみてください。MIST工法®カビバスターズ東京が、安心できる室内環境づくりの第一歩をサポートいたします。
目次
なぜ「カビの調査・検査(見える化)」が必要なのか
「カビ臭い」「苦情が出ている」その段階こそ、数値で現状を把握することが重要です
「なんとなくカビ臭い気がする」「以前より空気が重く感じる」「従業員や利用者から体調や臭いについての苦情が出ている」
このような状況は、建物内でカビ問題がすでに進行している可能性を示す重要なサインです。しかし多くの場合、「見えるカビがないから大丈夫」「掃除をすれば問題ないだろう」と判断され、根本的な調査が行われないまま放置されてしまいます。
カビの厄介な点は、必ずしも目に見える場所に発生するとは限らないことです。壁の内部、天井裏、床下、空調内部など、普段確認できない場所で繁殖し、空気中に胞子を放出しているケースも少なくありません。その結果、原因がわからないままカビ臭や体調不良といった問題だけが表面化します。
そこで重要になるのが、カビの調査・検査による「見える化」です。
「ある・ない」の感覚的な判断ではなく、カビ菌の量や種類、空気中の状態を数値やデータとして把握することで、初めて現状を正確に理解することができます。これは、法人・施設管理者の方が社内説明や対策判断を行ううえでも、非常に重要なポイントです。
また、現代の建物は高気密・高断熱化が進んでおり、一度湿気や空気の滞留が起きると、カビが発生・拡散しやすい環境になっています。原因を特定しないまま表面的な対応をしても、再発のリスクが高いのが現実です。だからこそ、「気になる段階」で調査を行い、問題を数値で可視化することが、被害拡大を防ぐ最も確実な方法なのです。
「本当にカビが原因なのか知りたい」「どこから発生しているのか把握したい」
そう感じた時点で、専門的なカビ調査・検査を行うことが、安心できる室内環境への第一歩となります。
目に見えないカビ問題が建物内で起きている理由
壁の中・天井裏・空気の流れ――現代の建物ほどカビは潜みやすい
「目で見えるカビはないのに、なぜカビ臭いのか」「原因がはっきりしないまま不調や苦情が続く」
このようなケースは、カビが“見えない場所”で発生している可能性が高いと考えられます。
現代の建物は、省エネ性能を高めるために高気密・高断熱構造が主流です。一見すると快適な環境ですが、その反面、空気や湿気が逃げにくいという特徴があります。換気が不十分だったり、わずかな結露や漏水が起きたりすると、壁の内部や天井裏、床下などに湿気が溜まりやすくなります。こうした場所は普段目にすることができず、気づかないうちにカビが繁殖してしまうのです。
さらに厄介なのが、カビはその場に留まらず、空気中に胞子を放出するという性質を持っている点です。壁の中や天井裏で発生したカビでも、建物内の空気の流れに乗って室内全体に広がることがあります。その結果、見えるカビがなくても、室内がカビ臭く感じたり、人によっては喉の違和感や体調不良を訴えたりするケースが起こります。
また、エアコンや換気設備の内部、配管まわり、家具の裏側なども、湿気がこもりやすくカビが発生しやすいポイントです。これらは日常的な清掃では確認しづらく、「掃除しているのに改善しない」と感じる原因にもなります。
このように、現代の建物では“見えない場所”にカビが発生しやすい環境が整ってしまっているのが現実です。だからこそ、「目に見えない=問題がない」と判断するのは非常に危険です。見えないからこそ、調査によって内部の状態や空気環境を確認し、カビ問題が起きていないかを把握する必要があります。
カビの発生は、建物の構造・湿気・空気の流れなど、複数の要因が重なって起こります。原因を知らずに放置すると、問題は静かに進行し、後になって大きなトラブルへと発展することもあります。見えない段階で気づき、調べることが、カビ問題を深刻化させないための重要なポイントなのです。
カビ菌検査とは?法人・施設で求められる理由
感覚ではなく「数値」で判断することが、信頼性と安心につながる
「カビがあるかもしれないが、はっきりとはわからない」
「臭いの原因がカビなのか、別の問題なのか判断できない」
このような状況で、法人や施設の管理者が最初に行うべきなのがカビ菌検査です。
カビ菌検査とは、室内環境や空気中にどの程度のカビ菌(真菌)が存在しているのかを調べ、数値として可視化する調査です。目視や臭いといった主観的な判断ではなく、客観的なデータをもとに現状を把握できるため、法人・施設では特に重要視されています。
法人施設の場合、従業員や利用者の健康、安全、職場環境への配慮が求められます。
「なんとなく問題がありそうだから対策する」ではなく、
「検査結果で基準を超えている」「数値として異常が確認された」
という明確な根拠があることで、社内説明や意思決定がスムーズになります。
また、カビ菌検査は「今すぐ対処が必要な状態なのか」「経過観察で問題ないのか」を判断する材料にもなります。過剰な対応を避けつつ、必要な対策を見極めるためにも、現状を正しく知ることが欠かせません。
特に近年は、
・オフィス
・医療機関
・福祉施設
・保育園・学校
・商業施設
など、不特定多数の人が利用する建物において、室内環境への意識が高まっています。カビ問題は見過ごされがちですが、空気環境の悪化として現れ、クレームや信頼低下につながることもあります。
「見えない」「確証がない」段階だからこそ、カビ菌検査によって状況を把握することが重要です。数値で現状を把握することで、初めて次の判断ができるようになります。それが、法人・施設におけるカビ対策の基本的な考え方なのです。
カビ同定検査で「どんなカビか」を知る意味
カビはすべて同じではない―種類を知ることがリスク判断につながる
一口に「カビ」と言っても、その種類は非常に多く、性質や影響もさまざまです。
「カビ菌検査で数値が出たから安心」「量が少ないから問題ない」
そう思われがちですが、どの種類のカビが存在しているのかを知らなければ、正しい判断はできません。そこで重要になるのがカビ同定検査です。
カビ同定検査とは、検出されたカビ菌がどのような種類の真菌なのかを特定する検査です。種類によって、健康への影響の大きさ、繁殖しやすい環境、再発のしやすさなどが異なります。そのため、量だけでなく「質」を把握することが、カビ問題を正しく理解するためのポイントになります。
例えば、空気中に常在する比較的影響の少ないカビもあれば、湿気の多い環境で急激に増殖しやすいカビ、建材の奥深くまで入り込む性質を持つカビも存在します。見た目や臭いだけでは、これらを区別することはできません。
法人や施設においては、従業員や利用者の健康への配慮が求められるため、「どんなカビが存在しているのか」を把握することは非常に重要です。特に、体調不良やアレルギー症状、臭いに関する苦情が出ている場合、カビの種類を特定することでリスクの程度を冷静に判断できます。
また、カビ同定検査は「なぜこの場所でカビが発生しているのか」を考えるヒントにもなります。種類によって好む湿度や温度、発生しやすい環境が異なるため、建物のどこに問題があるのかを推測する材料になります。原因を考えずに表面的な対応だけを行うと、現代の建物では再発する可能性が高くなってしまいます。
「とりあえず調べる」ではなく、「正しく知る」ための検査。
カビ同定検査は、見えないカビ問題を一歩深く理解するために欠かせない調査なのです。
空気質測定でわかる室内環境の現状
「臭い」「不調」の正体は空気中に浮遊するカビ菌かもしれません
「部屋に入った瞬間、なんとなく嫌な臭いがする」
「長時間いると喉がイガイガする、頭が重くなる」
こうした症状や違和感は、空気中の環境悪化が関係していることがあります。その原因の一つとして見逃せないのが、空気中に浮遊するカビ菌です。
空気質測定とは、室内の空気環境を調べ、目に見えない空気中の状態を数値で把握する調査です。カビは発生した場所に留まらず、胞子という非常に小さな粒子を空気中に放出します。この胞子は、人の動きや空調、換気の流れに乗って室内全体へ広がっていきます。そのため、壁の中や天井裏など、見えない場所で発生したカビでも、空気を通じて影響が現れるのです。
空気質測定を行うことで、
・室内空気がどのような状態にあるのか
・カビ菌がどの程度空気中に存在しているのか
といった点を、感覚ではなくデータとして確認できます。
「臭いの正体がカビなのか」「換気不足なのか」「別の要因なのか」を切り分けるためにも、空気環境の把握は非常に重要です。
特に法人施設やオフィスでは、複数の人が同じ空間を長時間利用します。そのため、空気環境の悪化は、個人の問題ではなく職場環境全体の問題として表面化しやすく、苦情や不信感につながることもあります。空気質測定によって現状を把握しておくことは、管理者にとって大きな安心材料になります。
また、空気質測定は「今すぐ問題がある状態なのか」「将来的に注意が必要な状態なのか」を判断する目安にもなります。目に見えるカビがなくても、空気中の状態から隠れたカビリスクが浮かび上がるケースも少なくありません。
「なんとなくおかしい」と感じる空間ほど、空気を調べてみる価値があります。
空気質測定は、見えないカビ問題を可視化し、次の判断につなげるための重要な調査なのです。
一般社団法人微生物対策協会と連携した真菌検査の重要性
「正確な検査結果」でなければ、正しい判断はできません
カビ問題の調査・検査において、非常に重要なのが検査結果の信頼性です。
いくら検査を行っても、その方法や評価基準が曖昧であれば、現状を正しく把握することはできません。だからこそ、カビ調査では信頼できる検査体制と専門機関との連携が欠かせないのです。
真菌(カビ菌)は非常に種類が多く、空気中や建物内に常在しているものも少なくありません。そのため、「検出された=すぐに危険」と短絡的に判断するのではなく、検出量・種類・環境条件を総合的に評価する必要があります。ここで重要になるのが、微生物に関する専門的な知見です。
MIST工法®カビバスターズ東京では、一般社団法人微生物対策協会と連携した真菌検査を重視しています。専門機関と連携することで、検査結果の信頼性が高まり、「今の室内環境がどのような状態なのか」「どの程度注意が必要なのか」を冷静に判断する材料を得ることができます。
特に法人や施設の場合、
・従業員や利用者への説明
・社内外への報告
・管理責任としての判断
が求められる場面も多く、「なんとなくの調査結果」では通用しません。第三者性・専門性のある検査体制は、管理者にとって大きな安心材料となります。
また、真菌検査は「今ある問題」を把握するだけでなく、将来的なリスクを見極めるための指標にもなります。現時点では大きな問題がなくても、環境条件次第でカビが増殖しやすい状態が見えてくることもあります。早い段階で状況を知ることで、被害が大きくなる前に対策を検討することが可能になります。
カビ問題は、感覚や経験だけで判断すると見誤りやすい分野です。
だからこそ、信頼できる真菌検査によって現状を正しく知ることが、安心できる室内環境づくりへの近道なのです。
壁の中まで確認するファイバースコープ調査とは
「見えないから大丈夫」を防ぐ、内部状態の可視化調査
カビ調査で多くの方が驚かれるのが、
「見える場所はきれいなのに、内部で問題が起きているケースが非常に多い」
という点です。そこで重要な役割を果たすのが、ファイバースコープを用いた調査です。
ファイバースコープ調査とは、壁や天井、床下などの内部に小さなカメラを入れ、目視では確認できない場所の状態を直接確認する調査方法です。外から見ただけでは判断できない、建物内部の湿気の状況や汚れ、カビの発生有無を把握することができます。
現代の建物では、
・配管まわり
・断熱材の裏側
・結露が起きやすい外壁面
など、カビが発生しやすい条件が内部に集中しています。しかし、これらの場所は日常点検では確認できず、「異常に気づいたときにはすでに広がっていた」というケースも少なくありません。
ファイバースコープ調査を行うことで、
「本当に壁の中は問題ないのか」
「カビ臭の原因が内部にあるのか」
といった疑問を、映像というわかりやすい形で確認できます。専門知識がない方でも状況を理解しやすく、調査結果に納得しやすい点も大きなメリットです。
また、内部の状態を確認せずに対処を進めてしまうと、原因を見落としたままになる可能性があります。現代の建物は一度内部に湿気やカビの原因が残ると、表面だけをきれいにしても再発のリスクが非常に高い構造になっています。そのため、「内部に問題がないか」を確認することは、原因追究のうえで欠かせません。
「見えない場所だから仕方がない」ではなく、
「見えない場所こそ確認する」
それが、カビ問題を根本から考えるうえでの重要な視点です。ファイバースコープ調査は、建物内部の状態を把握し、カビ発生の原因を突き止めるための大切な手段なのです。
建材の含水率検査がカビ発生原因の特定につながる理由
カビは「湿気」を見逃すと、何度でも繰り返します
カビ問題を考えるうえで、決して切り離せないのが湿気の存在です。
カビは湿度が高い環境を好み、特に建材に水分が含まれた状態が続くと、発生・繁殖のリスクが一気に高まります。そのため、カビ調査では建材の含水率検査が非常に重要になります。
含水率検査とは、壁や床、天井などの建材がどの程度水分を含んでいるのかを数値で測定する調査です。見た目では乾いているように見えても、内部に水分を溜め込んでいるケースは珍しくありません。こうした状態は、カビが発生しやすい「見えない温床」になってしまいます。
例えば、
・結露が繰り返し起きている外壁面
・配管まわりのわずかな漏水
・換気不足による湿気の滞留
などは、建材の内部にじわじわと水分を蓄積させます。その結果、表面には異常がなくても、内部でカビが繁殖し、後から臭いや空気環境の悪化として現れることがあります。
含水率を測定することで、
「どの部分に湿気が溜まっているのか」
「カビが発生しやすい状態が続いているのか」
といった点を客観的な数値で把握できます。これは、感覚や経験だけでは判断できない重要な情報です。
また、湿気の原因を突き止めずに対処を行ってしまうと、現代の建物では再発する可能性が非常に高くなります。表面的に問題が解消したように見えても、含水率が高い状態が続いていれば、再びカビが発生してしまうからです。
カビ対策において大切なのは、「今見えている問題」だけでなく、カビが発生した根本原因を見つけることです。建材の含水率検査は、その原因を探るための重要な手がかりとなります。
風量計による負圧検査で空気の流れを確認する
カビ菌は「空気の動き」に乗って広がる―見落とされがちな原因
カビ問題というと、「湿気」や「結露」に目が向きがちですが、もう一つ非常に重要な要素があります。それが建物内の空気の流れです。
実は、カビ菌は発生した場所だけに留まらず、空気の動きによって建物内に広がっていくという特徴を持っています。
そこで行われるのが、風量計を用いた負圧検査です。
負圧検査とは、室内と外部、または部屋同士の空気圧の差や空気の流れを測定し、どの方向に空気が動いているのかを確認する調査です。目に見えない空気の動きを数値で把握することで、カビ菌がどのように拡散している可能性があるのかを判断できます。
例えば、建物の一部が負圧状態になっていると、
・壁の中
・天井裏
・床下
といった空間から、空気が室内へ引き込まれやすくなります。もしその内部にカビが発生していれば、カビ菌を含んだ空気が室内に流れ込むことになります。これが、「見えるカビがないのに臭いがする」「特定の部屋だけ空気が悪く感じる」といった現象につながることもあります。
また、換気設備のバランスが崩れている場合や、給気と排気の量が適切でない場合も、意図しない空気の流れが生まれます。こうした状態では、せっかく清掃や管理を行っていても、空気の流れによって問題が再発・拡散してしまう可能性があります。
風量計による負圧検査を行うことで、
「どこから空気が入ってきているのか」
「どこへ空気が流れているのか」
といった点が明確になります。これは、カビが発生した原因を追究するうえで、湿気や建材の状態と並んで非常に重要な情報です。
カビ問題は、単一の原因だけで起きることはほとんどありません。
湿気・建物構造・空気の流れ――これらが重なった結果として発生します。空気の動きを把握せずに対処を行うと、現代の建物では再発する可能性が高くなります。
だからこそ、風量計による負圧検査で空気の流れを確認し、カビ菌が広がる仕組みを理解することが、根本的な原因改善につながるのです。
原因を追究せずに対処するとカビは再発する
現代の建物でカビトラブルが繰り返される本当の理由
「一度きれいにしたはずなのに、またカビ臭が戻ってきた」
「前回は問題なかったのに、数か月後に同じ苦情が出た」
このようなカビトラブルの再発は、決して珍しいことではありません。その大きな原因が、カビが発生した“本当の理由”を追究しないまま対処してしまうことにあります。
カビは、単に目に見える汚れではありません。
湿気・建物構造・空気の流れ・使用状況など、複数の要因が重なって発生します。表面に現れた症状だけを見て対応しても、壁の中や天井裏、床下などに原因が残っていれば、時間の経過とともに再び問題が表面化してしまいます。
特に現代の建物は、高気密・高断熱化が進んでいるため、一度内部に湿気や空気の滞留が生じると、自然に改善されることはほとんどありません。その結果、
・見えない場所でカビが残り続ける
・空気の流れに乗って再び室内へ影響が出る
といった状況が起こりやすくなります。
また、「とりあえず様子を見る」「一部だけ対応する」といった判断は、一時的に問題が落ち着いたように見えても、根本原因が解決されていなければ再発の可能性を高めてしまいます。これは、法人施設やオフィスにおいて、長期的な管理リスクにもつながります。
だからこそ重要なのが、
・カビ菌検査
・空気質測定
・建材の含水率検査
・ファイバースコープ調査
・負圧検査
といった調査を通じて原因を多角的に把握することです。これらの調査結果をもとに原因を理解しなければ、同じ問題を繰り返すことになってしまいます。
カビ問題は、「今どうなっているか」だけでなく、「なぜそうなったのか」まで考えることが非常に重要です。原因を追究する姿勢こそが、再発を防ぎ、安心できる室内環境を維持するための鍵となります。
「何度も同じトラブルが起きている」
「一度しっかり原因を知りたい」
そう感じたときこそ、専門的な調査を行うタイミングです。
原因改善を前提に考えることが、現代の建物におけるカビ対策の基本なのです。
カビ問題が心配な方に真菌検査をおすすめする理由
「問題が起きてから」ではなく「不安を感じた時」が調べどきです
「本当にカビが原因なのかわからない」
「大きな問題ではないかもしれないが、少し気になる」
このように感じている段階で、真菌検査を行うことは決して早すぎる判断ではありません。むしろ、カビ問題においては“ちょっとした違和感”を見逃さないことが非常に重要です。
カビは、目に見えるようになった時点で、すでに建物内に広がっているケースも少なくありません。そのため、「はっきりした被害が出てから調べる」のではなく、不安を感じた段階で現状を把握することが、被害拡大を防ぐ近道になります。
真菌検査をおすすめする理由の一つは、安心材料を得られることです。
検査の結果、特に問題がない状態であれば、「過度に心配する必要はない」と判断できます。反対に、注意が必要な状態であれば、早い段階で状況を把握し、次の対応を検討することができます。どちらの場合でも、「わからないまま悩み続ける」状態から抜け出せることが大きなメリットです。
特に、
・小さなお子様や高齢者が利用する空間
・多くの人が長時間過ごすオフィスや施設
・過去に結露や水漏れがあった建物
では、カビの影響が表に出にくい分、定期的な確認や早期調査が安心につながります。
また、真菌検査は「今すぐ対策が必要かどうか」を判断するための基準にもなります。感覚だけで判断すると、必要以上に不安になったり、逆に問題を軽く見てしまったりすることがあります。数値とデータで現状を知ることは、冷静な判断を行うために欠かせません。
「気のせいかもしれない」
「まだ大丈夫だと思う」
そう感じている今こそが、実は一番調べやすいタイミングです。
カビ問題が心配な方には、まず真菌検査による現状把握をおすすめします。それが、安心できる室内環境づくりの第一歩となるのです。
関東地方のカビトラブルはMIST工法®カビバスターズ東京へ
手に負えないカビ問題こそ、専門的な調査と原因追究が重要です
「どこに相談すればいいのかわからない」
「自分たちだけでは判断がつかない」
カビ問題に直面した多くの方が、このような悩みを抱えています。カビは目に見える被害だけでなく、空気環境や建物内部の状態に深く関わる問題であるため、専門的な知識と調査が欠かせません。
MIST工法®カビバスターズ東京は、関東地方のカビトラブル解決を専門とし、オフィス・店舗・医療施設・福祉施設・集合住宅・一般住宅まで、さまざまな建物のカビ問題に向き合ってきました。「カビ臭い気がする」「原因がわからない」「再発を繰り返している」といった段階でのご相談も多く寄せられています。
カビ問題で大切なのは、今見えている現象だけにとらわれないことです。
カビ菌検査、真菌検査、空気質測定、建材の含水率検査、ファイバースコープ調査、風量計による負圧検査など、調査を通じて建物全体の状態を把握しなければ、根本原因は見えてきません。原因を追究せずに対処を行うと、現代の建物では再発の可能性が高くなってしまいます。
また、一般社団法人微生物対策協会と連携した真菌検査により、信頼性の高いデータに基づいた判断ができることも、安心につながる大きなポイントです。感覚や経験だけに頼らず、数値と根拠をもとに現状を理解することで、冷静な判断が可能になります。
「今すぐ何かをしなければならないのか知りたい」
「まずは状況を把握したい」
そう感じたときは、決して一人で悩まず、専門家に相談してください。問題が小さいうちに調べることが、結果的に時間や負担を抑えることにつながります。
手に負えないカビトラブル、判断に迷うカビ問題は、
MIST工法®カビバスターズ東京へ。
関東地方の建物環境を守るパートナーとして、安心できる第一歩をお手伝いいたします。
■カビ検査・カビ調査・カビ取り・除菌などカビの事なら何でもお任せください■
-------カビ対策専門のカビバスターズ東京---------
対応エリア:東京・神奈川・千葉・埼玉・栃木・群馬・山梨・静岡・長野
お客様専用フリーダイヤル:0120-767-899
TEL:050-5527-9895 FAX:050-3131-0218
株式会社ワールド|カビバスターズ東京
【本社】〒152-0004 東京都目黒区鷹番1丁目1-5 フラットフォー本社ビル4F
【世田谷営業所】〒157-0067 東京都世田谷区喜多見2丁目5-1 PenthouseTB2F